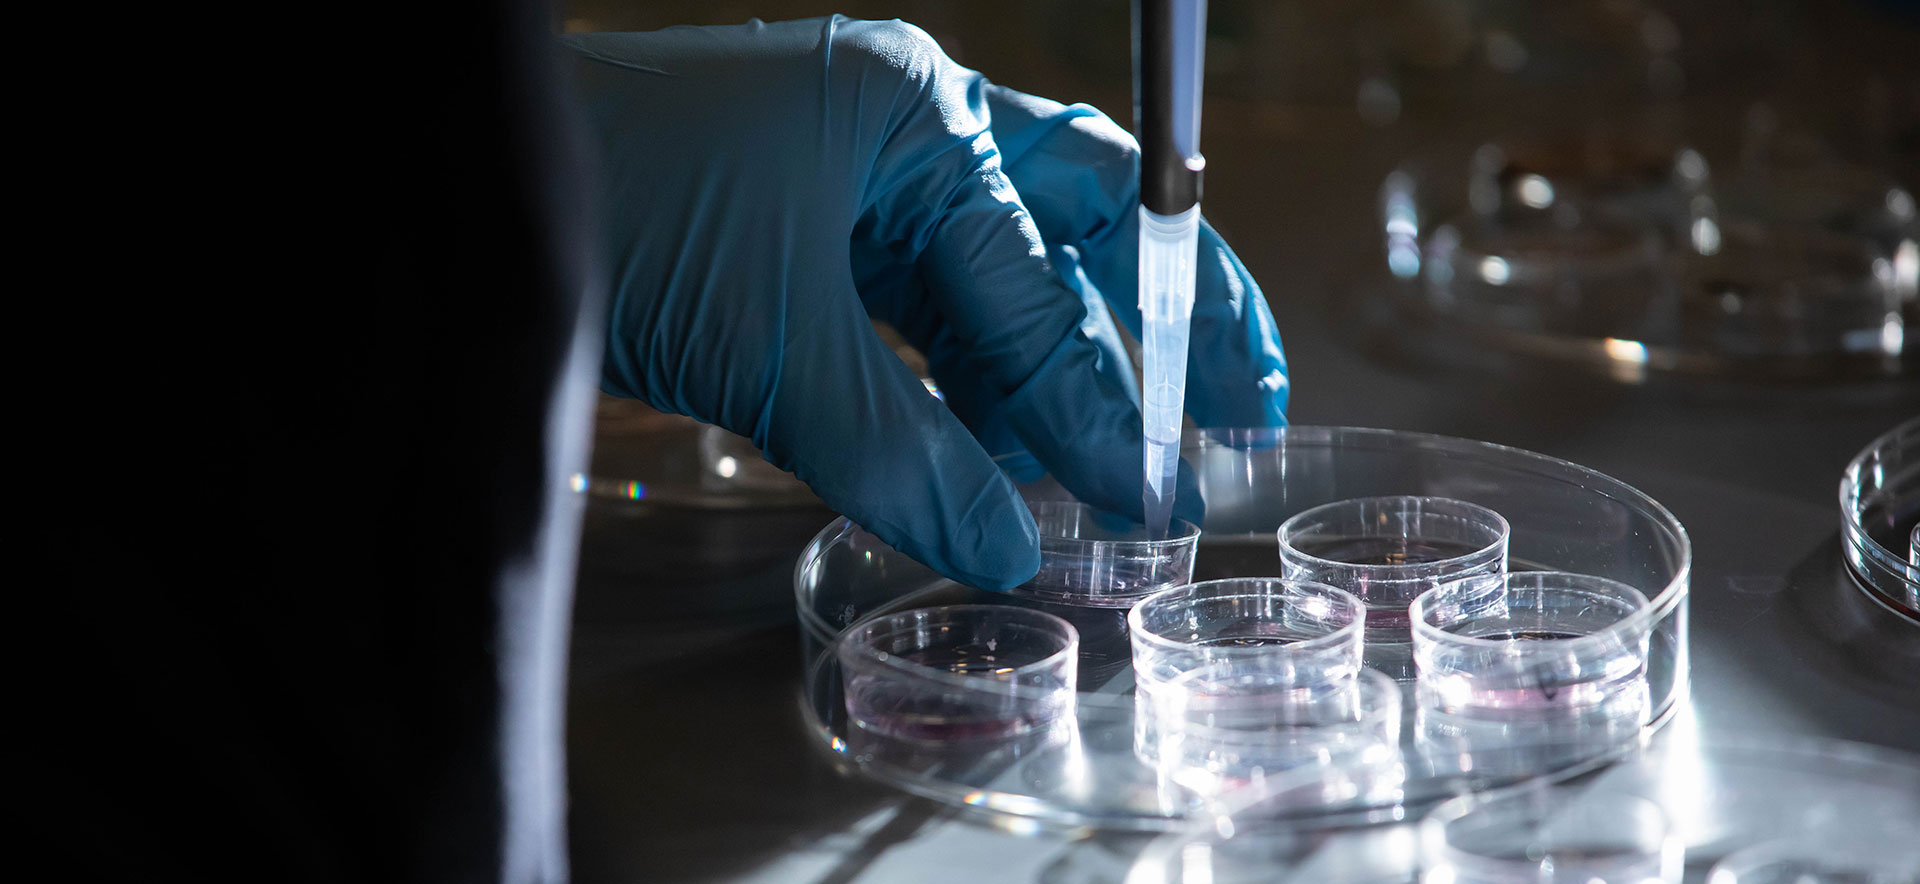
A close up of science equipment in a lab

Explore, collaborate, discover
A commitment to improving human lives is the engine of our research enterprise.
Brandeis is an R1 research university, one of just 71 members of the Association of American Universities, an organization of elite research institutions in North America on the leading edge of scientific innovation and wellbeing.
Across 15 scientific fields and multiple social science and policy fields, from the humanities to the arts, Brandeis faculty are making discoveries that deepen our understanding of our world and our ability to solve problems.
Our major funding sources include the National Science Foundation, the National Institutes of Health, the Department of Energy and the Howard Hughes Medical Institute. We are also a National Science Foundation funded Materials Research Science and Engineering Center (MRSEC), one of only 24 universities nationwide to receive this award.
Research Across Disciplines
Faculty Research
Brandeis’ world-renowned faculty bring their passion for interdisciplinary research, teaching and mentoring into every lab and classroom, educating the next generation of leaders while advancing their own fields through discovery.
Honors and Awards
Our faculty have received the highest honors in their fields, including the Nobel and Kavli Prizes and the National Medal of Science. They are members of organizations such as the National Academy of Sciences, the National Academy of Medicine, the American Academy of Arts and Sciences, and the American Association for the Advancement of Science. Several are also Howard Hughes Medical Institute Investigators and Professors.

Student Research
 Our students, who conduct research alongside these leading faculty, are regularly recognized with top honors. In 2025, the Fulbright Foundation designated Brandeis as a “Top Producing Institution of Fulbright U.S. Students.” Our Fulbright-funded research includes projects on swarm robots in Japan; race, gender and class in South Korea; and autism spectrum disorder in India.
Our students, who conduct research alongside these leading faculty, are regularly recognized with top honors. In 2025, the Fulbright Foundation designated Brandeis as a “Top Producing Institution of Fulbright U.S. Students.” Our Fulbright-funded research includes projects on swarm robots in Japan; race, gender and class in South Korea; and autism spectrum disorder in India.
In addition to the Fulbright, our students frequently garner awards and fellowships such as the Goldwater, Marshall, Truman, Boren, and Critical Language Scholarship.
Undergraduates also lead their own research projects alongside faculty and have co-authored hundreds of peer-reviewed research articles in scientific journals. The Undergraduate Research and Creative Collaborations Office helps students find topics, mentors, and funding for original research or creative projects.
Graduate students enjoy small classes, faculty mentorship and collaboration. Our graduate schools offer scholarships, grants, fellowships and internships, as well as lifetime career support.
Centers and Institutes
Brandeis faculty research problems from the profound to the practical. Our centers and institutes are dedicated to addressing many of the most pressing issues affecting society today, including promoting peace in the Middle East; solving the opioid crisis; expanding health-care access, and developing entrepreneurship and innovation.